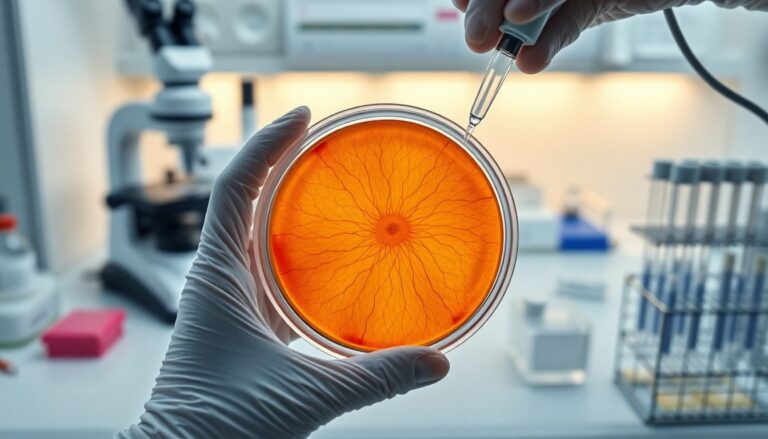

Investigadores de la Universidad Johns Hopkins han recreado en laboratorio la formación de la región central de la retina, identificando un proceso químico en dos fases que determina la alta resolución visual y abre vías para terapias regenerativas
Un equipo científico ha logrado cultivar retinas humanas en laboratorio utilizando organoides retinianos, lo que ha permitido desentrañar cómo se organiza la región responsable de la visión más nítida. Este avance, liderado por la Universidad Johns Hopkins, aporta una explicación molecular sobre la formación de la foveola, la pequeña zona central de la retina que concentra gran parte de la percepción visual.
La reproducción en 3D de tejido retiniano a partir de células humanas ha abierto la posibilidad de seguir el desarrollo celular durante semanas o meses, algo que los modelos animales tradicionales no permiten con fidelidad. Gracias a estos modelos, los investigadores han observado cambios celulares y señales químicas que hasta ahora eran especulativos.
Qué es la zona central y por qué importa
La foveola es una depresión microscópica en el centro de la retina que soporta funciones clave como la lectura y el reconocimiento de rostros. En términos prácticos, es la parte del ojo que ofrece la máxima agudeza visual. Por eso, su deterioro en enfermedades como la degeneración macular central provoca pérdida severa de la visión en actividades cotidianas.
Comprender cómo se genera la distribución específica de los fotorreceptores —especialmente los conos rojos y verdes que predominan en la fóvea— es esencial para diseñar terapias que intenten restaurar tejido dañado o sustituir células perdidas.
El mecanismo en dos fases descubierto
Los experimentos realizados sobre los organoides revelaron una secuencia molecular en dos pasos que determina la identidad de los conos en la región central. En primer lugar, el ácido retinoico, un metabolito de la vitamina A, actúa limitando la aparición de conos de tipo azul en la zona que dará lugar a la fóvea. Posteriormente, las hormonas tiroideas promueven la transformación de las células residuales hacia fenotipos de conos rojos y verdes.
Este modelo implica una conversión celular en lugar de un simple desplazamiento de células hacia los márgenes, una idea que cuestiona la hipótesis mantenida durante décadas. Los datos obtenidos indican que algunas células inicialmente con características de conos azules modifican su identidad funcional bajo la influencia combinada de estas señales químicas.
Observaciones clave en organoides
Al monitorear el crecimiento y la diferenciación en los organoides, los investigadores pudieron documentar el momento y la localización de los cambios: durante ventanas concretas del desarrollo embrionario temprano, los niveles de ácido retinoico y de hormona tiroidea regulan el destino celular. Este control temporal contribuye a la arquitectura precisa de la fóvea humana.
Implicaciones para la medicina regenerativa
Descifrar estas señales moleculares tiene implicaciones directas para la terapia celular en patologías que afectan la visión central. Los organoides ofrecen una plataforma para generar poblaciones específicas de fotorreceptores —por ejemplo, conos rojos o verdes— con la identidad adecuada para futuros trasplantes.
Los autores del estudio, entre ellos el profesor Robert J. Johnston Jr., destacan que la técnica facilitará la producción de células a medida para reemplazar tejido retiniano dañado. Aun así, existen desafíos pendientes: garantizar la integración funcional de células trasplantadas, su supervivencia a largo plazo y la seguridad antes de cualquier ensayo clínico.
Limitaciones y pasos siguientes
Aunque los hallazgos suponen un avance importante, los expertos subrayan que los organoides no reproducen la totalidad del microambiente del ojo adulto. Por ello, la investigación continuará optimizando estos modelos y evaluando la eficacia de estrategias de reemplazo celular en sistemas más complejos y, posteriormente, en modelos clínicos controlados.
En conjunto, este progreso demuestra que la biología del desarrollo combinada con técnicas de cultivo avanzado puede brindar rutas plausibles hacia tratamientos de la degeneración macular y otras enfermedades retinianas, consolidando a los organoides como herramientas fundamentales en la investigación oftalmológica.

